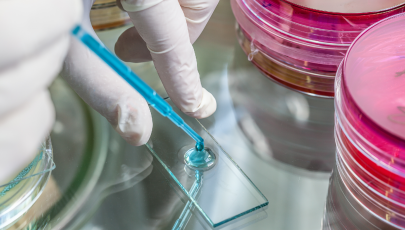

Infeção respiratória
O que é?
Ocorre quando uma parte do aparelho respiratório é infetada por um microrganismo que pode ser um vírus, uma bactéria, um fungo ou um parasita. As suas manifestações dependem da área atingida. De facto, todas as partes do aparelho respiratório podem sofrer uma infeção: nariz (rinite); seios peri nasais (sinusite); faringe (faringite); laringe (laringite); brônquios (bronquite, bronquiectasias); pulmão (pneumonias) e pleura (pleurite).
Embora a maioria sejam benignas, elas são muito frequentes e podem ser fatais. Por exemplo, as pneumonias são a terceira causa de mortalidade humana e a tuberculose ocupa o sétimo lugar. À escala mundial, as infeções respiratórias são responsáveis por cerca de quatro milhões de mortes todos os anos.
Elas podem ter um impacto variado, dependendo da sua frequência e da gravidade. As mais importantes são as pneumonias, as agudizações infeciosas da doença pulmonar obstrutiva crónica, a tuberculose e a gripe.
Em Portugal, estima-se que ocorram anualmente, mais de 800 mil casos de infeções respiratórias, 150 mil das quais são pneumonias. Em 2008 registaram-se mais de 50 mil internamentos por pneumonia, tendo falecido mais de quatro mil pessoas por esta doença, o que a torna a terceira causa de mortalidade no país.
Sintomas
Os sintomas vão depender da localização da infeção e da sua gravidade. As queixas mais comuns são a congestão e corrimento nasal, a tosse, dores de garganta e no corpo, fadiga e febre. De um modo geral, os sintomas iniciam-se um a três dias após exposição ao agente. Pode ocorrer associação com conjuntivite, no caso de infeção causada por alguns vírus, e com dor de cabeça ou facial, no caso da sinusite.
Em casos mais avançados pode surgir dificuldade respiratória, tonturas, alterações da consciência. Estes sintomas traduzem, de um modo geral, uma dificuldade na chegada de oxigénio aos pulmões e exigem uma avaliação urgente.
Causas
Estando em contato direto com o meio exterior, o aparelho respiratório está permanentemente exposto a agentes infeciosos que o podem atingir por via inalatória (através do ar que respiramos) por via circulatória (através da circulação) ou por aspiração de material infetado proveniente da boca e/ou das vias aéreas superiores.
São fatores de risco uma redução das defesas, como acontece nas crianças, nos idosos ou em doentes com quadro de imunodeficiência (VIH ou cancro).
Dentro dos diversos microrganismos que podem causar infeção respiratória, os vírus são os mais comuns. Dentro das bactérias, as mais frequentes são o Streptococcus pneumoniae, Mycoplasma pneumoniae, Haemophilus influenzae e Chlamydophila pneumoniae.
Diagnóstico
O exame médico é essencial na avaliação da infeção respiratória. Em muitos casos, não são necessários exames adicionais e o tratamento pode ser prontamente definido.
Em situações mais graves, poder ser pedida uma radiografia ou uma tomografia computorizada. Outros testes que podem ser úteis são as provas de função respiratória e o estudo laboratorial da expetoração ou de outras amostras para se tentar identificar o agente responsável pela infeção.
Tratamento
O tratamento depende da localização, dos fatores de risco e do agente responsável. Para as infeções causadas por vírus, não existem medicamentos específicos e o tratamento baseia-se no alívio das queixas. Podem ser úteis analgésicos, descongestionantes nasais ou remédios para a tosse. No caso das bactérias, existem diversas classes de antibióticos que devem ser sempre selecionadas pelo médico.
É muito importante, face a uma infeção respiratória, não começar logo um antibiótico porque, em muitos casos ele não é útil e aumenta-se desnecessariamente o risco de efeitos secundários e de resistência a futuros tratamentos.
Prevenção
Embora o aparelho respiratório disponha de mecanismos de defesa contra os diversos microrganismos, eles nem sempre são suficientes. A manutenção de um estilo de vida saudável, com uma alimentação equilibrada, praticar exercício físico, não fumar, entre outros aspetos, é essencial na sua prevenção.
O fumo do tabaco diminui a atividade das células que destroem as bactérias que penetram no aparelho respiratório e, como tal, é um importante fator de risco para a infeção respiratória. A existência de ar de baixa qualidade favorece a ocorrência de infeções e é um veículo para a transmissão de microrganismos. Por isso, é muito importante evitar locais mal ventilados, sobrepovoados e poluídos, com ar excessivamente seco, muito frios e muito húmidos, ou mudanças bruscas de temperatura, tal como condições climáticas agressivas (frio, chuva, humidade e vento).
Existem atualmente medicamentos que pertencem à família das vacinas e que ajudam a aumentar a resistência às infeções respiratórias. Estes fármacos têm a capacidade de estimular a atividade das principais células e protegem o aparelho respiratório das infeções. Habitualmente são administrados por via oral.
Fundação Portuguesa do Pulmão, 2012
Centers for Disease Control and Prevention, Agosto de 2013
The Cleveland Clinic Foundation, 2013
Mayo Foundation for Medical Education and Research, Abril de 2013